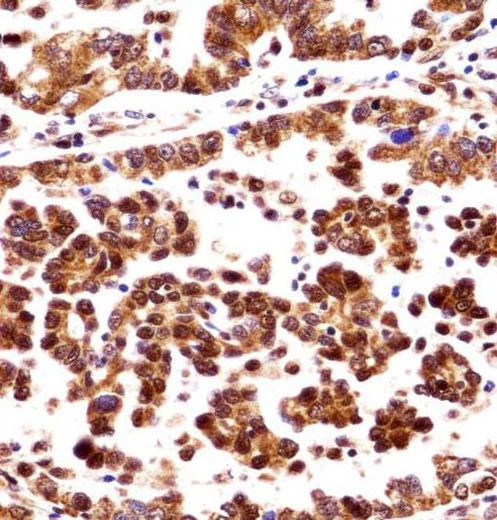
ORC3 Antibody in Immunohistochemistry (Paraffin) (IHC (P))

Search
Invitrogen
ORC3 Polyclonal Antibody
{{$productOrderCtrl.translations['antibody.pdp.commerceCard.promotion.promotions']}}
{{$productOrderCtrl.translations['antibody.pdp.commerceCard.promotion.viewpromo']}}
{{$productOrderCtrl.translations['antibody.pdp.commerceCard.promotion.promocode']}}: {{promo.promoCode}} {{promo.promoTitle}} {{promo.promoDescription}}. {{$productOrderCtrl.translations['antibody.pdp.commerceCard.promotion.learnmore']}}
产品信息
PA5-35161
宿主/亚型
分类
类型
抗原
偶联物
形式
浓度
保存条件
运输条件
RRID
靶标信息
Histone deacetylase 2 (HDAC2), or transcriptional regulator homolog RPD3 L1, is highly homologous to the yeast transcription factor RPD3 (reduced potassium dependency 3) gene. As in yeast, human HDA2 is likely to be involved in regulating chromatin structure during transcription. It has been implicated to associate with YY1, a mammalian zinc-finger transcription factor, which negatively regulates transcription by tethering RPD3 to DNA as a cofactor. This process is highly concerved from yeast to human.
仅用于科研。不用于诊断过程。未经明确授权不得转售。